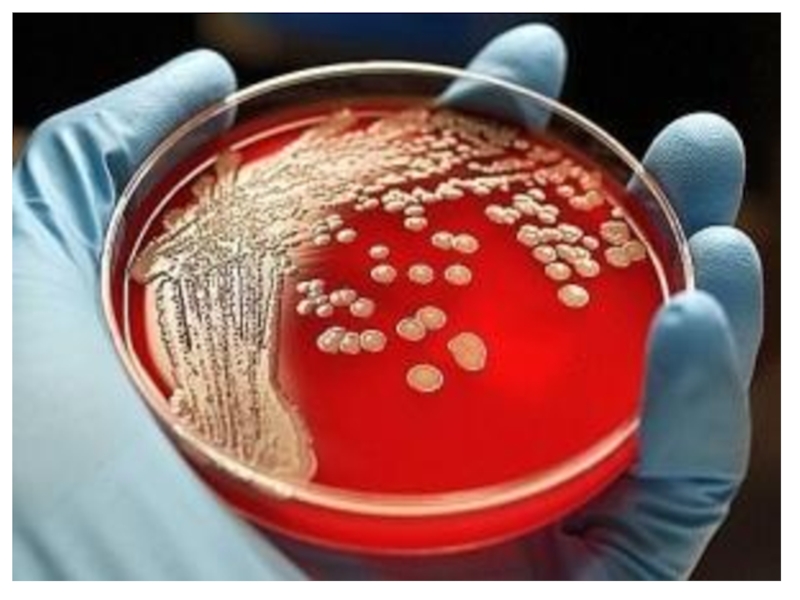

Слайд 1
М.Оспанов атындағы Батыс Қазақстан Мемлекеттік
Медицина Университеті
Кафедра: ЖТД интернатурасы мен дипломнан кейінгі білім беру
кафедрасы
Дисциплина: Балалар аурулары.
Тақырыбы: Балаларда Helicobacter pylori-инфекциясымен шақырылған асқорыту жолының жоғары бөлігін емдеу
схемасы.
Орындаған: Жәнділдаева Нұржамал
706 топ
Тексерген: Досимов Арыстан
Жоспары:
Кіріспе:
Хеликобактер пилори сипаттама
Негізгі бөлім:
Патогенезі,диагностикалық критерийі
Диагностикасы
емі
Қорытынды:
Пайдаланылған әдебиет тізімі
Слайд 31983 жылы ғалымдар алғаш рет микроорганизмнің жаңа түрін ашты-Helicobacter Pilori.
Бұл микроорганизм асқазан қабырғасының қабынуын тудыруға қабілетті. Бұл бактериялар шырышты
қабықтың қорғаныштық қабатын зақымдайтын көптеген ферменттер (уреаза,протеаза,фосфолипаза) және әртүрлі цитотоксиндер өндіреді.
Ол негізінен грамм теріс , талшықтары бар, спираль пішінді бактериялар.Бактериялардың инфицирленуі асқазан қабынуын, одан кейін асқазан-ішек жолдарының ауруларын тудырады. Асқазанның шырышты қабатындағы интерлейкиннің, лизосомальді энзимнің, асқазан шырышты қабатындағы қабыну тудыратын ісік некроздаушы фактордың шығуына әсер етеді.
Слайд 5Нр – Жұғу отбасында немесе фекальды-оральды жолмен, таза емес эндоскоп,
зонд арқылы асқазанға кіреді. НР асқазанның антральды бөлігін жайлайды, сонан
кейін денесіне, 12 елі ішекке жайғасады. Вирулентті факторлар түзеді (муциназа, фосфолипаза А, уреаза, токсиндер) СО2 және аммиак бөлініп, ол эпителийді жарақаттайды Асқазан рН (қышқылдығы) жоғарылайды, J-клеткалар гастринді көп түзіп, секреция күшейтеді . Қабыну процессі дамиды, ІgA, цитокининдер түзіледі . Осындай өзгерістер 12 елі ішекте де болады. 12 елі ішек асқазан-ішек жолының “гипофизі” болғандықтан , гормондар түзілісі бұзылады, моторика мен секреция өзгереді.
Диагностикалық критерий:
Асқазандағы ауырсыну (әлсіз,сыздап ,қанжар
сұққандай күшті ауырсыну), тамақ қабылдағаннан кейін.
Жүрек айну
Кекіру
Құсу
Асқазандағы ауырлық сезімі
Іш қату
Ауырсыну тамақтанған соң азаюы
Тәбеті төмендеу
Тоқтық сезім
Слайд 10 Науқас шағымдары:
іш ауруы қатты, жиі, ұстама
тәрізді, эпигастрий маңында. Ауру сезімі көбінесе ашқарынға білініп, тамақтан соң
азаяды.
Өршу мерзімдігі: әдетте қыркүйек-қазан айлары – мектепке барып, тамақтану стереотипіне байланысты, ал наурыз-сәуірде науқастардың метеолабильдігіне байланысты көрінеді.
Слайд 12 Хеликобактер диагностикасы
Инвазивті
(Биопсия қажет)
Гистологиялық
Бактериоскопиялық
Бактериологиялық
Биохимиялық (уреаза
тесті)
Инвазивті емес
Серологиялық
ПТР-полимеразды тізбекті реакция
Тыныстық
Hp антигенін нәжісте анықтау
Бактериологиялық диагностикалау әдісі
Бұл әдіс
биопсия алу арқылы, себіндіні арнайы ортада яғни Хеликобактер пилориді өсіру арқылы жүргізіледі. 100% нақты бактерияны табуға мүмкіндік беретін нағыз зерттеу әдісі болып табылады. Бактериологиялық әдіс антибиотикке тұрақтылықты анықтауға және динамикалық бақылау жүргізуге мүмкіндік береді. Ғылыми тәжірибеде бактериологиялық әдіс Хеликобактер пилоридің патогенділік факторын анықтауға, серологиялық әдіс үшін препарат дайындауға, эпидемологиялық және өзгеде зерттеулер үшін штамм банк құруға мүмкіндік береді, бактерия штамдарын мұздатылған күйде -70 градус температурада 5-7 жыл сақтауға болады. Алайда, бұл әдіс өте қымбат болып табылады. Сонымен қатар,ол біршама қиындықтар тудырады,арнайы ортаны, оңтайлы температура мен ылғалдылықты, атмосфералық ауаның сапасын жане т.б қажет етеді. Бұл оңтайлы жағдайлар болмаса, микрорганизмнің өсуі болмайды. Әдістің кемшілігі нәтижесін 10-14 күннен кем емес күтілуінде. Хеликобактер пилори өте кірпияз, ол арнайы қолайлы жағдайлар мен қымбат жабдықтарды талап етеді. H.Pilory-ді сәтті өсіру жолындағы ең үлкен қадамына тасымалдау ортасы жатады, себебі бұл орта эндоскопиялық кабинеттен микробиологиялық лабораторияға жеткізу кезінде тәулікке дейін сақтауға көмегін тигізеді.(Стюрт орта, Кэри-Блейера, Био-Мерьо ортасы.)

Слайд 16Келесі қадам-селективті және селективті емес биоптат себіндісінен тұрады. Себінді 37
градус температурада,98% ылғалдылықта микроаэрофильді жағдайда 3-10 күн тәулікте өседі. Хеликобактер
пилори өсетін атмосфера 5 % оттегі, 5-10% көмірқышқыл газынан және қалғаны азоттан тұрады.Қажетті PH 6.7 дан 8.0 дейін. Инкубация кезеңі: біріншілік зерттеу-7 күн, емді бақылау-14 күн. Селективті емес қоректік ортада Хеликобактер пилори 1-3 мм , ұсақ формалы,дөңгелек, тегіс,мөлдір және 3-5 күнде өседі.Селективти қоректік ортада алтын сары түспен боялған,трифенилтетразолий хлориді ортасы әсерінен.
Серологиялық диагностикалау әдісі
Хеликобактер пилори инфекциясын диагностикалауда серологиялық зерттеудің ішінде кең таралғаны ИФА болып табылады. Инвазивті емес және жанама әдіс науқас қанындағы Хеликобактер пилориге қарсы түзілетін антиденені анықтау үшін Ig A/IgM –ді жиі IgGді анықтайды.Әдістің сезімталдығы 87 ден 98%-ға дейін, арнайылығы 75-дан 100% дейін ауытқиды.
ИФА-эпидемологиялық зерттеу және скрининг үшін ен жарамды әдіс болып табылады. Оны қолдану арқылы клиникалық тәжірибеде науқастағы нақты мәселені шешімін табуға болады.
диагностикалау әдісі
Гистологиялық зерттеу жоғары сенімділікке немесе науқастың асқазанында хеликобактер инфекциясы
жоқтығын, әсіресе иррадикациялық шараларынан кейін мүмкіндік береді.Әсіресе, алғаш жаралы ауру диагнозында қан кетуімен маңызды шиеленістіріп, хеликобактерия инфекциясымен жаралы асқазанды байланыстыру мүмкін емес. Бұл жағдайда диагностикалық алгоритм , емдеу жолдамаларын анықтау шараларында, хеликобактер бактериялары айқындалуы
маңызды. Биопсиялық материалдың микроскопиялық зерттеу хеликобактерия инфекцияларын ғана емес, асқазанның әр бөліктерінің сілемейлі қабықшаларының өзгеру құрамын сипаттайды, тін және инфекцияның қарама-қайшы орналасқанын бағалап, белсенділік реакциясын шығарады.Диагнозды нақтылау үшін, күдік туғызатын ошақтардан биоптат алынып,гистологиялық зерттеулер жүргізіледі. Ережесі бойынша биоптат саны 5-тен кем болмау керек:
2 антральдік бөліктен, қалтқыдан ә см жоғары, асқазан денесінен кардийден 8 см қашық, артқы және алдыңғы қабырғаларынан және асқазанның бұрышынан.Негізінен бұл гистологиялық әдіс хеликобактериоз диагнозының алтын стандарты болып табылады. НР гематоксилин-эозинмен немесе арнайы бояулармен анықтайды.Дайын болған жағындыны микроскопқа салу арқылы анықталады.

Бактериоскпиялық
зерттеу
Ол үшін цитологиялық әліс қолданылады. Цитологиялық тексеруге асқазан
кілегей қабығы биоптатының жағынды-таңбасы қолданылады.
Жағындыларды Романовский Гимза бойынша бояйды. Хеликобактериялар
кілегейде орналасады, спираль тәрізді немесе иілген түрі.
НР өсуінің 3 дәрежесін бөледі:
Әлсіз + ---көру алаңында 20 дейін микроб денесінің болуы:
Орташа++ ---50 дейін микроб денесінің болуы:
Жоғары+++ ---50-ден көп микроб денесінің болуы.
Биохимиялық диагностикалау әдісі
Ол ушін уреазалық тест қолданылады. Уреазалық тестіні қолдану НР
уреазаны бөлетінімен байланысты: бөлінген уреаза асқазан сөліндегі
мочевинаның әсерінен ыдырап, аммоний бөледі. Аммоний иондары ортаның
рн-ын арттырады, оны индикатор көмегімен анықтауға болады.
Ол үшін экспресс – уреазалық әдіс қолданылады.
Экспресс жинақта мочевина болады. Биоптатта хеликобактер болса,
орта таңқурай түске боялады.Таңқурай түстің пайда болу уақытына қарап,
НР санын анықтайды.
+ инфекцияның саны өте аз /таңқурай түсі тәуліктің соңында пайда болады.
++ инфекция саны орташа/2 сағат ішінде байқалады.
+++ инфекция саны ауқымды./таңқурай түсі бірінші сағат ішінде білінеді.
--- Теріс мәнді нәтиже/1 тәуліктен кейін байқалады.

Емі:
Медикаментозды емес:
Аурудың өршуі кезінде төсектік режим
Физикалық және психикалық тыныштық
Емдәм асқазанды механикалық, химиялық, термиялық аяушылықпен, сөліністі қоздыратын тағамсыз, бөлікті тамақтандыру керек. Тағам құрамынан ащы қосындылар, ас тұзы және холестеринге бай тағамдар алынып тасталады. Аурудың жедел сатысында 1 а, 1б, 1 емдәмдер қолданылады.
Слайд 25Асқазан сөлінің құрамының жаугершілік қасиетін төмендететін дәрілер:
антацидті дәрілер:
гелюксил-лак, алмагель, гестал ,фосфалюгель, маалокс, мегалак, викаир, викалин т.б. күніне 3-4
рет тамақтан алдында 1.5-2 сағат бұрын және ұйқы алдында, курс 2-3 апта.
Слайд 27Н+, К+, АТФ-аза – протондық насос ингибиторлары: омепразол, пантопразол,
лансопразол, лосек, лопрал, нексикум. Күніне 1-2 рет,
2 апта бойы,0.5-1
мг/кг есебінен тағайындалады.
Слайд 28Н2 –гистаминоблокаторларының 2-3 ұрпағы қолданылады: ранитидин, фамотидин, гастросидин тәулігіне 40
мг/кг, роксатидин 2-40 мг. Низатидин, аксид 20-40 мг/кг.
Слайд 29Селективті м-холинолитиктер пиренцепин, гастроцепин 2-3 апта бойына ертеңгісін және кешкісін
25 мг, риабол күніне 1 мг/кг-нан 3 рет қолданылады.
Слайд 30Спазмолитиктер: папаверин, но-шпа, дюспаталин.Спастикалық ауырсынуларда эпизодты қолданылады.
Дофамин антагонистері: церукал 2-5
мг, мотилиум 5-15 мг. 10-14 күн бойына
рефлюкс байқалғанда тамаққа
дейін және түнге қарай қолданылады.
Слайд 31Нр инфекциясын емдеу Халықаралық консенсус (Маастрихт – 2,2000) ұсынысына сай
жүргізіледі.
Балаларға арналған ұсыныстар:
-Нр инфекциясы балаларда созылмалы гастрит туғызады
Нр инфекциясы
балаларда ойық жара ауруымен тіркес -Нр эрадикацисы созылмалы гастриттен жазылуға әкеледі
Нр эрадикациясы ойық жара ауруының ұзақ ремиссиясына әкеледі
Жоғарғы асқазан ішек жолдарының ауру симптомдары органикалық дертке келсе, тексерудің ең қажеттісі ФЭГДС пен биопсия болуы тиіс, т.б.
Слайд 32Нр (Хеликобактер пилори) эрадикациясы Үштік ем: (Протондық насос ингибиторы +2
антибиотик қолданылады)
І қатар
ПНИ + амоксициллин + кларитромицин
ПНИ
+ амоксициллин + метронидазол
ПНИ + кларитромицин + метронидазол
Слайд 33Төрттік (квадро ем) ем
(Протондық насос ингибиторы+ 2 антибиотик+ коллоидтық
висмут препараты)
Де-нол + ПНИ + амоксициллин + метронидазол
Пилорид
+ кларитромицин + метронидазол
Ем тиімділігіне 4 апта өткен соң баға беріледі.
Слайд 34
Қолданылған әдебиеттер:
А.С. Калмыкова Поликлиническая
педиатрия
Москва,2009
Е.Т. Дадамбаев Емханалық педиатрия
Т.К. Кулмаханов Алматы,1998
Интернет желісі www.google.kz